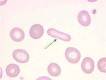
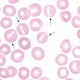
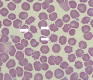
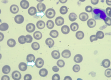
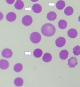

: drepanocitos
: drepanocitos
 : dacriocitos
: dacriocitos
: eliptocitos
: eliptocitos
: estomatocitos
: estomatocitos
 : esquizocitos
: esquizocitos
: acantocitos
: acantocitos
: codocitos
: codocitos
: esferocitos
: esferocitos
Otros juegos similares:
Otros juegos similares:
Otros juegos similares:






















